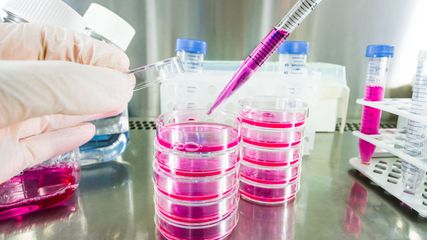

Videos
60 Jahre Swiss Cancer Institute (SCI)
Im Rahmen eines Festakts am 11. September 2025 in Bern, feierte das SCI sein 60-jähriges Bestehen. Neben anderen Ehrengästen erklären Präsident Prof. Miklos Pless und CEO Vincent Gruntz ...
«Durch die Young Oncology Academy konnte ich mir ein Netzwerk aufbauen»
Die Young Oncology Academy der SAKK ist ein Förderungs- und Mentorship-Programm für junge Onkolog:innen. Wir haben mit dem ehemaligen Teilnehmer Dr. med. Jonas Lötscher gesprochen.
«Es war eine unglaubliche Erfahrung für mich»
Die Young Oncology Academy der SAKK ist ein Förderungs- und Mentorship-Programm für junge Onkolog:innen. Wir haben mit der ehemaligen Teilnehmerin Dr. med. univ. Chiara Louisa Hempel ...
10 Years of Young Oncology Academy
On the occasion of the 10th anniversary of the Young Oncology Academy, we spoke with SAKK President Prof. Dr. med. Miklos Pless, who initiated the YOA’s founding.
Pract. med. Alexander Meisel
Pract. med. Alexander Meisel im Interview
CLL: Update wichtiger Studien
Neue Daten zu den Studien CLL12 – CLL14 – MURANO
Lymphome: ASCO- und EHA-Highlights
Hodgkin-Lymphom – diffus großzelliges B-Zell-Lymphom – primär mediastinales großzelliges B-Zell-Lymphom
Lymphome: ASCO- und EHA-Highlights
Hodgkin-Lymphom – diffus großzelliges B-Zell-Lymphom – primär mediastinales großzelliges B-Zell-Lymphom.
ASCO-Highlights zum Mammakarzinom
monarchE-Studie: auch ältere HR+/HER2- EBC-Patient:innen profitieren von CDK4/6-Inhibition – PALMIRA-Studie: „Treatment beyond progression“ mit CDK4/6-Inhibitor HR+/HER2- ABC nicht empfohlen
Analysen zu Biomarkern beim Prostatakarzinom
Update PEACE-1: Lokale Radiotherapie beim mCSPC? – Biomarker-Kohorte in TALAPRO-2: PARP-Inhibitor zu Enza beim mCRPC?
Fortschritte in der Therapie des Endometriumkarzinoms
RUBY-Trial: QoL-Erhalt und besseres Outcome hinsichtlich Schmerzen unter Therapie mit Dostarlimab bei Patientinnen mit Endometriumkarzinom und Mismatch-Repair-Defizienz
Rolle des Mikrobioms in der Hämatopoese
Welchen Einfluss haben Mikrobiom und Inflammation auf die Genese hämatologischer Erkrankungen?
Personalisiere Therapie mittels funktionaler Assays
Neues zur EXALT-2-Studie: Entwicklung individueller Therapien durch „Single-cell functional precision medicine“ und „Comprehensive genomic profiling“
Spannende Ergebnisse aus der MM-Grundlagenforschung
Neubewertung prognostischer Faktoren der Zeit zur Progression von MM-Patient:innen mit High-Risk-Features
MM: CAR T-Cells und bispezifische AK
CARTITUDE-4-Studie: Hohe Responseraten von CAR T-Cell vs. Standard of Care – KarMMa-Studie: QoL-Vorteil von CAR T-Cell vs. AK-Therapie
MDS: Was gibt es Neues?
IMerge-Studie: Phase-III-Daten zu Imetelstat bei EOP-refraktären Patient:innen – COMMANDS-Studie: 1st-Line Luspatercept vs. EPO
ASCO-Highlights zu gynäkoonkologischen Tumoren
Beim diesjährigen ASCO-Kongress wurden v.a. zum Ovarialkarzinom viele spannende Daten präsentiert, etwa aus der DUO-O-Studie.
Was gibt es Neues in der Therapie von Sarkomen?
Chemotherapie + Immuntherapie – Einsatz von „Breitspektrum“-TKI – klassische Chemotherapie
Neue Daten zu gastroösophagealen Tumoren
Prof. Aysegül Ilhan-Mutlu über ihre Highlights zu gastroösophagealen Tumoren: die Studien ATTRACTION-05 und INNOVATION.
AML: Effizientere CAR T-Zell-Therapie
Dr. Haubner, New York, präsentierte die Ergebnisse einer experimentellen Studie zur gezielten Optimierung einer CAR T-Zell-Therapie am humanisierten AML-Mausmodell.
Venetoclax-Obinutuzumab für therapienative CCLL-Patient:innen
Erstautor, Dr. Al-Sawaf aus Köln, kommentiert die präsentierten 6-Jahresdaten der CLL14-Studie.
Begrüßung der Kongresspräsidentin
Zum Auftakt des EHA-Kongresses sprach Prof. Döhner, Ulm, einleitende Worte zur Begrüßung aller Teilnehmer:innen.
Neuroonkologische Highlights beim ASCO
INDIGO-Studie: bahnbrechende Ergebnisse mit IDH1/2-gerichteter Therapie bei Gliomen – Einzug der Immunonkologie in der Gliom-Behandlung – BRAF-Inhibition bei Astrozytomen und Astroblastomen
Zusammenhänge bei der Onkogenese und in der Immuntherapie
Welche Rolle spielt das Mikrobiom in der Onkogenese und bei der Entwicklung neuer therapeutischer Ansätze? PD Maximilian Bösch, St. Gallen, gibt Einblick in den Stand der Forschung.
Promising developments in endometrial cancer research
Dr. Ilaria Colombo of the Oncology Institute of Southern Switzerland discusses the ASCO highlights concerning endometrial cancer: Survival outcomes for dostarlimab in GARNET as well as ...
Highlights zu Lymphomen
Assoc.Prof. Dr. Thomas Melchardt, PhD zu diesjährigen Highlights des ASCO und EHA im Bereich der Lymphome, darunter die Ergebnisse der Studien SHINE und ECHELON-1
EHA-Highlights zur CLL
Priv.-Doz. Dr. Daniel Heintel schildert im Videointerview seine Highlights des EHA 2022 zur chronischen lymphatischen Leukämie. Hochinteressant waren die Ergebnisse der Studie CLL13 aus ...
Forschungsergebnisse zur Sarkomtherapie
Univ.-Prof. Dr. Thomas Brodowicz erläutert im Interview u.a. die Ergebnisse der Studie rEECur zur Therapie des Ewing-Sarkoms, die beim ASCO Annual Meeting 2022 in der Plenary Session ...
Besser verträgliche Bridging-Therapie für ältere, fitte Patienten mit AML
Prof. Dr. Michael Lübbert vom Universitätsklinikum Freiburg über die Ergebnisse von 10-tägigem Decitabin im Vergleich zu konventioneller Chemotherapie als Bridging-Therapie für ältere, ...
EHA: Akademische CAR-T-Zell-Therapie für das multiple Myelom
Dr. Carlos Fernández de Larrea im Kurzinterview über die akademische BCMA-gerichtete CAR-T-Zell-Therapie mit ARI0002H beim multiplen Myelom und seine Hoffnung für die Zukunft dieser ...
Late Breaking Abstract zur CLL: GAIA/CLL13-Studie
Prof. Dr. Barbara Eichhorst von der Uniklinik Köln spricht im Kurzinterview über die Ergebnisse der CLL13-Studie. Diese präsentierte sie beim EHA 2022 in der Late Breaking Abstract Session.
Die wichtigsten EHA-Studien zu MPN
OA Dr. Thamer Sliwa gibt einen Überblick über die wichtigsten EHA-Daten zu myeloproliferativen Neoplasien, darunter die Ergebnisse von MOMENTUM zu Myelofibrose sowie ASCEMBL zu CML.
Multiples Myelom beim EHA 2022 – Was waren die Highlights?
Univ.-Prof. Dr. Heinz Ludwig spricht im Interview über die Highlights des EHA 2022 zum Multiplen Myelom, u.a. die Subgruppenanalyse der DETERMINATION-Studie und die ATLAS-Studie. Er ...
Innovationen in der Brustkrebstherapie
Univ. Prof. Dr. Michael Gnant fasst die Highlights des ASCO Annual Meetings 2022 zur Mammakarzinom-Therapie zusammen. Besonders die DESTINY-Breast04 Studie bei low-Her2-Patientinnen ...
Tumoren des oberen Gastrointestinaltrakts – die wichtigsten Studien
Ap. Prof. Priv.-Doz. Dr. med. univ. et scient. med. Aysegül Ilhan-Mutlu gibt einen Überblick über die wichtigsten ASCO-Studien zu Tumoren im Bereich des oberen Gastrointestinaltrakts.
Highlights zum Lungenkarzinom
OA Dr. Maximilian Hochmair berichtet von den spannendsten Studien zum Lungenkarzinom beim ASCO Annual Meeting 2022 – darunter CHRYSALIS und CHRYSALIS-2, COSMIC-021 sowie SKYSCRAPER-02.
Helicobacter pylori - was ist neu?
Auch ohne Symptome: Die neueste Leitlinienempfehlung sieht bereits in der Diagnose einer vorliegenden H.-pylori-Infektion eine Indikation zur Therapie. Prof. Dr. med. Peter Malfertheiner ...
Asthma & COPD: Der Weg zur zielgerichteten Therapie
Auch in der Therapie obstruktiver Atemwegserkrankungen hält nach und nach die individualisierte Medizin Einzug. Prof. Dr. med. Claus F. Vogelmeier, Marburg, fasst in seinem Referat die ...
Morbus Crohn & Colitis ulcerosa: Was ist neu für die Praxis?
Prof. Dr. med. Herbert Tilg, Innsbruck, erläutert, welche praxisrelevanten Neuerungen es in der Therapie von Morbus Crohn und Colitis ulcerosa gibt. So haben zum Beispiel die JAK- ...
Leitlinien-Update Herzinsuffizienz: neue medikamentöse Therapieoptionen
Die Therapie der Herzinsuffizienz befindet sich aktuell im Umbruch. Prof. Dr. med. Michael Böhm, Homburg/Saarland, erklärt den Paradigmenwechsel, der in den jüngsten Leitlinien zum ...
Telemedizinische Behandlung von CED-Patienten
Univ.-Prof. Dr. Herbert Tilg, Innsbruck, spricht über seine Eindrücke des 17. Kongresses der ECCO und fasst seinen Vortrag über die Zukunft der telemedizinischen Behandlung von CED- ...
Aktuelle Daten zu myeloproliferativen Neoplasien
Priv.-Doz. Dr. Sonja Heibl spricht im Videointerview über wissenswerte Studienergebnisse zu myeloproliferativen Neoplasien vom ASH-Meeting 2021.
Eine Fülle an neuen Daten zur akuten myeloischen Leukämie
PD Dr. med. Boris Schleiffenbaum spricht über die wichtigsten Studien vom ASH-Kongress zur akuten myeloischen Leukämie.
Rasante Entwicklung beim multiplen Myelom
Assoc. Prof. Priv.-Doz. Dr. med. Maria Krauth spricht im Video über ihre persönlichen Highlights vom ASH 2021 zur Therapie des multiplen Myeloms.
Highlights vom ASH-Kongress zu Lymphomen
Assoc. Prof. Dr. Thomas Melchardt spricht im Video-Statement über die ASH-Highlights zu Lymphomen.
Highlights vom ESMO-Kongress 2021
Univ.-Prof. Dr. Christian Singer fasst im Video alle wichtigen und praxisrelevanten Highlights vom ESMO-Kongress zum Mammakarzinom zusammen, darunter die Studien DESTINY-Breast03, ...
ESMO-Update von Dr. Hochmair
OA Dr. Maximilian Hochmair gibt im Video ein Update zu den wichtigsten Studien vom ESMO-Kongress zum Lungenkarzinom und Covid-19 bei onkologischen Patienten.
Mammakarzinom-Highlights vom ASCO 2021
Frau Prof. Marija Balic gibt im Interview einen Überblick über die wichtigsten ASCO-Studien zum Mammakarzinom.
ASCO-Highlights zum Lungenkarzinom
Im Interview berichtet OA Dr. Maximilian Hochmair von den wichtigsten am virtuellen ASCO-Kongress präsentierten Studien zum Lungenkarzinom.
Highlights zu Kopf-Hals-Tumoren
Im Interview erläutert PD Dr. med. Sacha Rothschild aktuelle Daten vom ASCO20 Virtual zu Kopf-Hals-Tumoren.
Die wichtigsten ASCO-Studien zum Lungenkarzinom
Im Interview spricht OA Dr. Maximilian J. Hochmair über die wichtigsten ASCO-Studien zum Lungenkarzinom.
Mammakarzinom-Highlights vom ASCO
ABCSG-Präsident Univ.-Prof. Dr. Michael Gnant gibt im Interview einen Überblick über die wichtigsten Studien vom ASCO20 Virtual zum Mammakarzinom.
ASCO-Highlights zum Prostatakarzinom
Im Interview berichtet PD Dr. med. Aurelius Omlin von den wichtigsten am virtuellen ASCO-Kongress präsentierten Studien zum Prostatakarzinom.
Highlights vom ASCO zu Lymphomen
Herr Prof. Dr. med. Christoph Renner spricht im Interview über die Ergebnisse der am ASCO-Kongress vorgestellten Studien zu Lymphomen.
ORION-Trials: Inclisiran – neue Option zur Lipidsenkung mit guten Studiendaten
Im Rahmen des ACC-Kongresses 2020 wurden von Prof. Scott Wright per Livestream spannende gepoolte Daten aus dem ORION-Studienprogramm zu Inclisiran präsentiert. Natürlich schätze ich im ...
Spannende neue Daten zur Lipidsenkung mit Inclisiran vom ACC-Kongress
Im Gespräch mit LEADING OPINIONS fasst Prof. Christian Müller die Ergebnisse einer gepoolten Analyse zu Inclisiran prägnant zusammen und teilt auch seine persönliche Sicht auf die ...
Von GINA bis GOLD
Wir sprachen mit Prof. Dr. Jörg Leuppi, Liestal, über die Konsequenzen des GINA-Updates 2019 für die klinische Praxis und die Adhärenz behandelnder Ärzte gegenüber den GOLD-Empfehlungen ...
Paradigmenwechsel in der CLL-Therapie
Dr. Jeroen S. Goede gibt im Interview ein Update zu den am EHA-Meeting präsentierten CLL-Daten und deren Relevanz für die klinische Praxis.
Interview mit PD Dr. med. Antonia Maria Müller
Dr. Müller berichtet im Gespräch über die aktuellen Studiendaten zur Stammzelltransplantation.